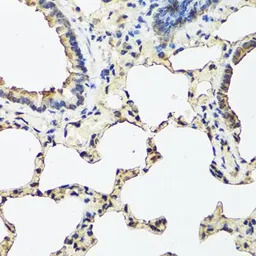
产品细节图片1
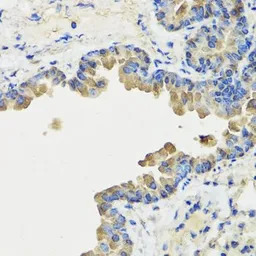
产品细节图片3

相关产品推荐更多 >
万千商家帮你免费找货
0 人在求购买到急需产品
- 详细信息
- 文献和实验
- 技术资料
- 免疫原:
Recombinant fusion protein containing a sequence corresponding to amino acids 27-175 of human REG3A (NP_002571.1).
- 亚型:
IgG
- 形态:
Liquid
- 保存条件:
Store as concentrated solution. Centrifuge briefly prior to opening vial. For short-term storage (1-2 weeks), store at 4ºC. For long-term storage, aliquot and store at -20ºC or below. Avoid multiple freeze-thaw cycles.
- 克隆性:
Polyclonal
- 标记物:
Unconjugated
- 适应物种:
Human, Mouse, Rat
- 保质期:
12 months from the shipping date of the product.
- 抗原来源:
Human
- 目录编号:
GTX55778
- 级别:
Primary Antibodies
- 库存:
Available
- 供应商:
GeneTex
- 宿主:
Rabbit
- 应用范围:
WB, ICC/IF, IHC-P
- 浓度:
Batch dependent (Please refer to the vial label for the specific concentration.)
- 靶点:
REG III alpha
- 抗体英文名:
REG III alpha antibody
- 抗体名:
REG III alpha 抗体
- 规格:
100 μl
IHC-P analysis of rat lung tissue using GTX55778 REG III alpha antibody.
Dilution : 1:100

IHC-P analysis of mouse stomach tissue using GTX55778 REG III alpha antibody.
Dilution : 1:100
IHC-P analysis of mouse lung tissue using GTX55778 REG III alpha antibody.
Dilution : 1:100

WB analysis of various sample lysates using GTX55778 REG III alpha antibody. The signal was developed with ECL plus-Enhanced.
Dilution : 1:1000
Loading : 25μg per lane

ICC/IF analysis of MCF7 cells using GTX55778 REG III alpha antibody.
Blue : DAPI
风险提示:丁香通仅作为第三方平台,为商家信息发布提供平台空间。用户咨询产品时请注意保护个人信息及财产安全,合理判断,谨慎选购商品,商家和用户对交易行为负责。对于医疗器械类产品,请先查证核实企业经营资质和医疗器械产品注册证情况。
 文献和实验
文献和实验% ),这使得化学合成siRNA 的成本升高。体外转录制备长片断RNA 并不难,但是由于研究表明长片断的双链RNA (>29bps )在哺乳动物细胞中通常会引发抗病毒反应―― 一种非特异基因表达抑制,而目前体外转录往往无法制备小于29bp 的小分子siRNA s 。一个新的研究发现,用RNase III 降解长片断双链RNA 成为siRNA s 库也能够有效诱导特异的基因沉默,这样可以避免了筛选有效siRNA s 的漫长过程,从而快速,经济的实现特定基因表达的沉默。在线虫、果蝇和其他一些物种的RNA 干扰
Polymerase III in vitro Transcription
: 4.0 μl 5X Pol III transcription buffer 0.2 μl 0.1 M DTT 0.2 μl alpha amanatin (1 mg/ml) 0.2 μl RNAse Inhibitor H2O to a final volume of 16 microliters less the maximum volume of protein to be added. Aliquot the second mix to all reaction tubes
大鼠III型胶原(Collagen III)ELISA试剂盒 说明书
上海西唐生物科技有限公司 021-55229872, 65333639 www.westang.com 大鼠 III 型胶原 (Collagen III)ELISA 试剂盒 ( 用于血清、血浆、细胞培养上清液和其它生物体液内 ) 原理 本实验采用双抗体夹心 ABC-ELISA 法。用抗大鼠 Collagen III 单抗包被于酶标板上,标准品和样品中的 Collagen III 与单抗结合,加入
 技术资料
技术资料暂无技术资料 索取技术资料





![CARD12 antibody [GT1387]](https://img1.dxycdn.com/2023/0711/451/6106825198874858761-14.jpg!wh200)
![RUVBL2 antibody [N1C1]](https://img1.dxycdn.com/2023/0516/407/0466332107306928561-14.jpg!wh200)
![ELAVL2 antibody [HL1978]](https://img1.dxycdn.com/2023/0711/058/8406876405285858761-14.jpg!wh200)


